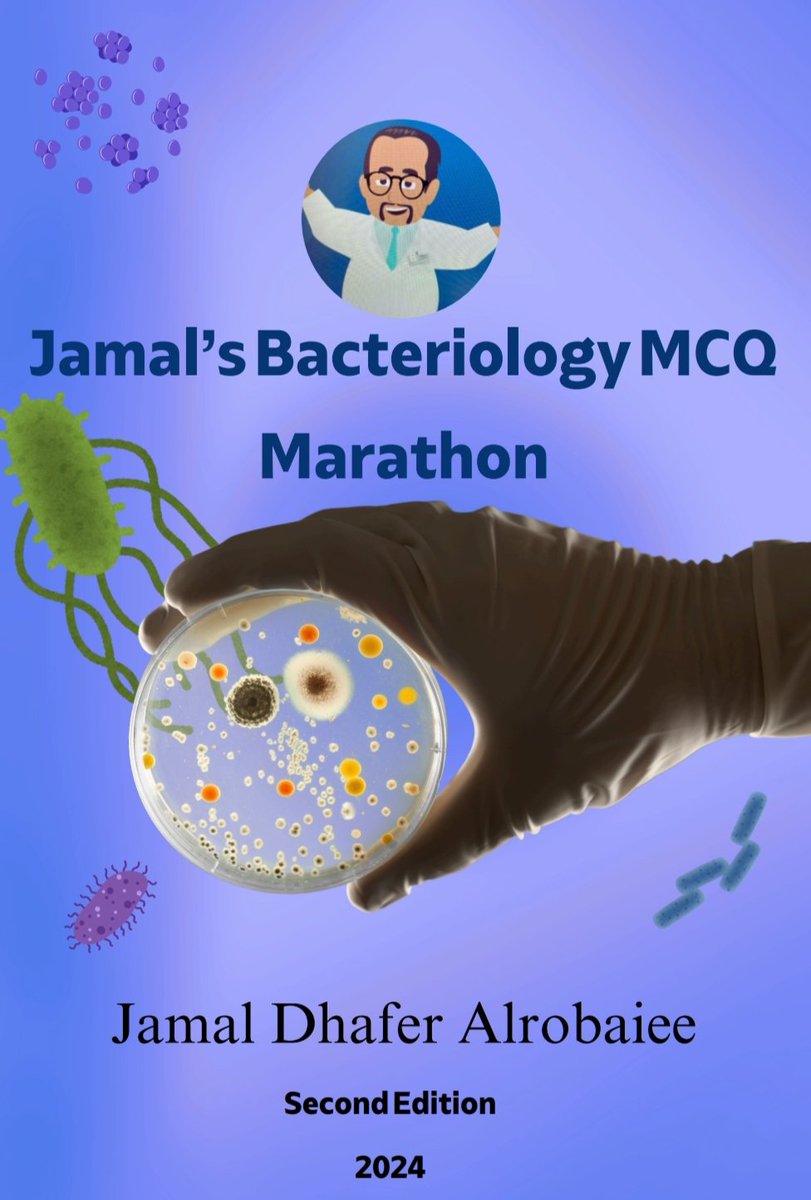
جمال الربيعي tweet media

جمال الربيعي
240 posts

@JamalMedTech
أخصائي مختبرات طبية | البورد الامريكي في الأحياء | مدرب معتمد TOT | كاتب ومؤلف لكتب طبية متخصصة في الأحياء الدقيقة | مفتش لدى كلية علماء الامراض الامريكية CAP

#قهوة_نواة انضموا إلينا في مساحة شيّقة بعنوان: عن الثقة بالموظف 💼 ما الذي يجعل المؤسسة تثق فيك 📌☕️ ! 🔹 ضيف اللقاء: أ. جمال ظافر الربيعي – مختص بعلم المختبرات الطبية 🔹 مقدم اللقاء: أ. أصايل الغامدي 📅 الأثنين 16 نوفمبر 2026 ⏰ 6:30 مساءً بتوقيت الرياض







بدأ التسجيل دورة المفاهيم الاساسية للجودة في المختبرات 4 فبراير 2026 شهادة حضور دولية شهادة حضور معتمدة من المؤسسة العامة للتدريب التقني والمهني للتسجيل futurksa.com/courses/68/cel… مركز المستقبل المعرفي للتدريب @futur_ksa نشوفكم على خير

سعدنا اليوم جميعاً في مستشفي القوات المسلحة بمنطقة الطائف (الهدى) بالحصول على اعتماد الCAP للمرة الخامسة عشرة، وهو إنجاز لمنسوبي المختبر وأن دل على شي فأنما يدل على مدى التزامهم بأعلى معايير الجودة.كل الشكر والتقدير لمنسوبي المختبر ولسعادة المقدم الدكتور عبدالله السليمان Dr. Abdullah Alsulaiman PhD , MBA® , GRCP, PMP®, CSci , CPHMG , CIL على هذا الانجاز.